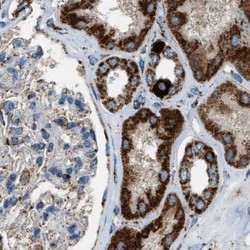

Antibody data
- Antibody Data
- Antigen structure
- References [2]
- Comments [0]
- Validations
- Western blot [3]
- Immunohistochemistry [5]
Submit
Validation data
Reference
Comment
Report error
- Product number
- NBP1-86036 - Provider product page

- Provider
- Novus Biologicals
- Proper citation
- Novus Cat#NBP1-86036, RRID:AB_11037554
- Product name
- Rabbit Polyclonal MDH2 Antibody
- Antibody type
- Polyclonal
- Description
- Immunogen affinity purified. Specificity of human MDH2 antibody verified on a Protein Array containing target protein plus 383 other non-specific proteins.
- Reactivity
- Human, Mouse, Rat
- Host
- Rabbit
- Isotype
- IgG
- Vial size
- 0.1 ml
- Storage
- Store at 4C short term. Aliquot and store at -20C long term. Avoid freeze-thaw cycles.
Submitted references A mouse model of L-2-hydroxyglutaric aciduria, a disorder of metabolite repair.
Molecular architecture of the chick vestibular hair bundle.
Rzem R, Achouri Y, Marbaix E, Schakman O, Wiame E, Marie S, Gailly P, Vincent MF, Veiga-da-Cunha M, Van Schaftingen E
PloS one 2015;10(3):e0119540
PloS one 2015;10(3):e0119540
Molecular architecture of the chick vestibular hair bundle.
Shin JB, Krey JF, Hassan A, Metlagel Z, Tauscher AN, Pagana JM, Sherman NE, Jeffery ED, Spinelli KJ, Zhao H, Wilmarth PA, Choi D, David LL, Auer M, Barr-Gillespie PG
Nature neuroscience 2013 Mar;16(3):365-74
Nature neuroscience 2013 Mar;16(3):365-74
No comments: Submit comment
Supportive validation
- Submitted by
- Novus Biologicals (provider)
- Main image

- Experimental details
- Western Blot: MDH2 Antibody [NBP1-86036] - Lane 1: NIH-3T3 cell lysate (Mouse embryonic fibroblast cells). Lane 2: NBT-II cell lysate (Rat Wistar bladder tumor cells).
- Submitted by
- Novus Biologicals (provider)
- Main image

- Experimental details
- Western Blot: MDH2 Antibody [NBP1-86036] - Analysis using Anti-MDH2 antibody NBP1-86036 (A) shows similar pattern to independent antibody NBP1-89540 (B).
- Submitted by
- Novus Biologicals (provider)
- Main image

- Experimental details
- Western Blot: MDH2 Antibody [NBP1-86036] - Analysis in HEK293 cells transfected with control siRNA, target specific siRNA probe #1,. Remaining relative intensity is presented. Loading control: Anti-PPIB.
Supportive validation
- Submitted by
- Novus Biologicals (provider)
- Main image

- Experimental details
- Immunohistochemistry-Paraffin: MDH2 Antibody [NBP1-86036] - Staining of human lymph node.
- Submitted by
- Novus Biologicals (provider)
- Main image

- Experimental details
- Immunohistochemistry-Paraffin: MDH2 Antibody [NBP1-86036] - Staining of human liver.
- Submitted by
- Novus Biologicals (provider)
- Main image
- Experimental details
- Immunohistochemistry-Paraffin: MDH2 Antibody [NBP1-86036] - Staining of human kidney.
- Submitted by
- Novus Biologicals (provider)
- Main image

- Experimental details
- Immunohistochemistry-Paraffin: MDH2 Antibody [NBP1-86036] - Staining of human colon.
- Submitted by
- Novus Biologicals (provider)
- Main image

- Experimental details
- Immunohistochemistry-Paraffin: MDH2 Antibody [NBP1-86036] - Staining of human colon, kidney, liver and lymph node using Anti-MDH2 antibody NBP1-86036 (A) shows similar protein distribution across tissues to independent antibody NBP1-89540 (B).